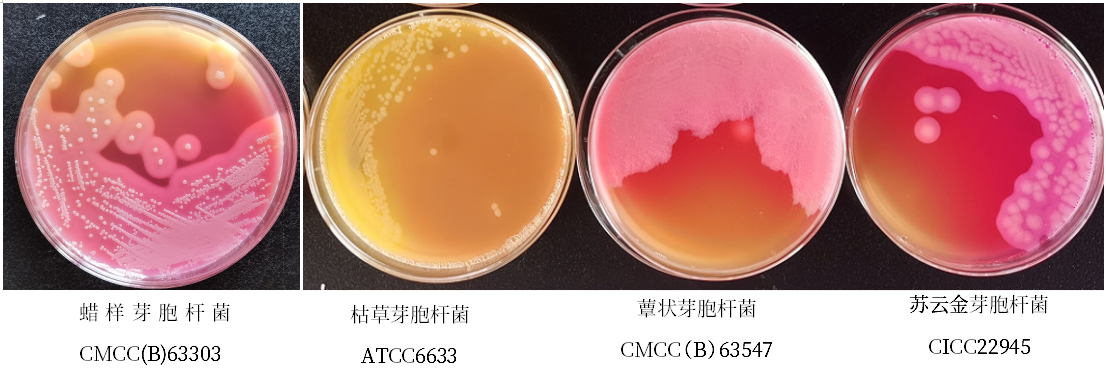
蠟樣芽胞桿菌檢測好幫手---蠟樣芽胞桿菌顯色培養基
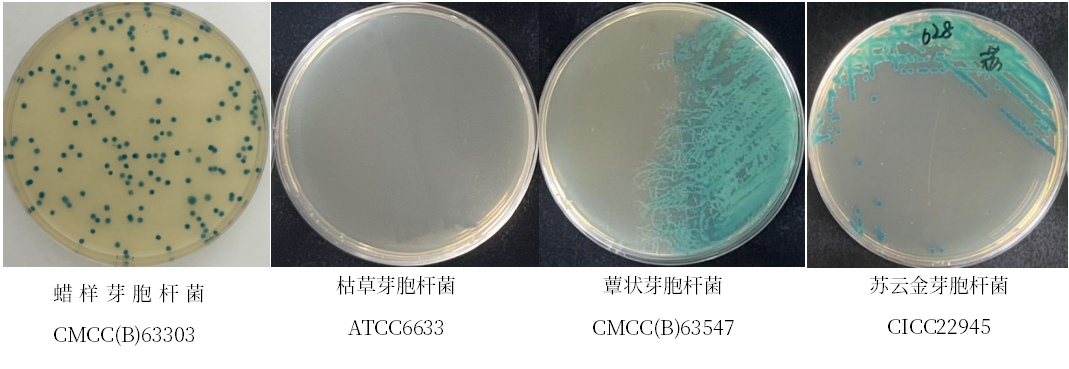
蠟樣芽胞桿菌檢測好幫手---蠟樣芽胞桿菌顯色培養基

蠟樣芽胞桿菌(Bacillus cereus)屬于芽胞桿菌屬����,會(huì )產(chǎn)生防御性的內芽胞�,是一種常見(jiàn)的食源性致病菌�。在自然界分布廣泛����,常存在于土壤��、灰塵和污水中����,植物和許多生熟食品中常見(jiàn)��?���?梢詮亩喾N食品中分離出該菌����,包括肉�、乳制品���、蔬菜�����、魚(yú)����、土豆�、醬油����、布丁�、炒米飯以及各種甜點(diǎn)等�。蠟樣芽胞桿菌是條件致病菌���,該菌可產(chǎn)生毒素���,主要為嘔吐毒素(蠟樣肽)和腹瀉毒素(腸毒素)����。人食用蠟樣芽孢桿菌污染的食品后�����,會(huì )產(chǎn)生嘔吐�����、腹瀉等癥狀��。
蠟樣芽胞桿菌檢驗在乳制品的監測中也起到了很重要的作用�����,它能夠從源頭掌握蠟樣芽胞桿菌的污染情況����,防止食源性疾病的發(fā)生��。
那么在現行國家標準中�,我們如何進(jìn)行蠟樣芽胞桿菌檢驗呢�?按照國家標準GB 4789.14-2014《食品安全國家標準 食品微生物學(xué)檢驗 蠟樣芽胞桿菌檢驗》��,檢驗流程如下:


標準中使用的分離或計數平板都為甘露醇卵黃多黏菌素(MYP)瓊脂�����,蠟樣芽胞桿菌的典型菌落形態(tài)為微粉紅色菌落�,周?chē)邪咨恋奂t色沉淀環(huán)��。而在MYP瓊脂平板上�����,其他芽胞桿菌也能夠較好的生長(cháng)�,尤其發(fā)酵甘露醇的芽胞桿菌為黃色菌落����,周?chē)囵B基變黃����,可能會(huì )干擾蠟樣芽胞桿菌的檢出���。
鑒于MYP的選擇性較弱�����,我們研制了兩款蠟樣芽胞桿菌顯色培養基����。顯色培養基利用特異性酶底物的反應原理��,具有更好的特異性和選擇性��。檢驗員們能夠更準確的識別蠟樣芽胞桿菌�����,并減少后續生化鑒定的工作量�。下面為大家展示一下不同菌株在兩款顯色培養基上的形態(tài)與MYP的區別����。

1���、ESM013 蠟樣芽胞桿菌顯色培養基
優(yōu)點(diǎn):相比MYP����,選擇性和特異性更強����,蠟樣芽胞桿菌有暈圈�,特征明顯�,容易識別����!

2�、ESM028 蠟樣芽胞桿菌顯色培養基(第二代)
優(yōu)點(diǎn):相比MYP�����,選擇性和特異性更強��,且可用于傾注法接種��,菌落更小��,方便觀(guān)察計數��。
綜上所述����,幾種分離培養基表現各有特點(diǎn)�����,建議各位檢測行業(yè)的同仁根據需要選擇使用����,也可以在使用MYP瓊脂的同時(shí)增加顯色培養基�,以便更好的保證蠟樣芽胞桿菌的檢出率���。據可靠消息�����,對GB 4789.14《食品安全國家標準 食品微生物學(xué)檢驗 蠟樣芽胞桿菌檢驗》的修訂工作已經(jīng)完成���,新標準中確定將應用蠟樣芽胞桿菌顯色培養基作為分離和計數平板��,這對各位同仁肯定是一個(gè)大好消息���,畢竟以后就再不用為了難以區分的可疑菌落而頭疼了���。我們一邊干活�,一邊期待新標準的發(fā)布吧�!
